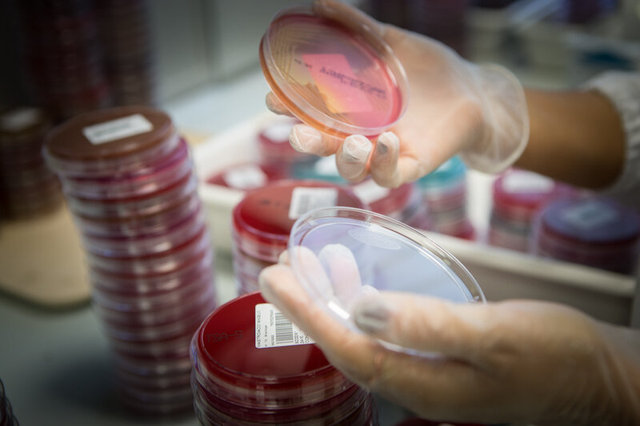
TAN_5375.jpg

TAN_3616-Modifica.jpg

TAN_3637.jpg

TAN_3886.jpg

TAN_3963-Modifica.jpg

TAN_3981.jpg

TAN_4067.jpg

TAN_4082.jpg

TAN_4097.jpg

TAN_4118.jpg

TAN_4165.jpg

TAN_4195.jpg

TAN_4300.jpg

TAN_4307.jpg

TAN_4466.jpg

TAN_4513.jpg

TAN_4580.jpg

TAN_4631.jpg

TAN_4720.jpg

TAN_4739.jpg

TAN_4816.jpg

TAN_4799.jpg

TAN_4788.jpg

TAN_4835.jpg

TAN_4843-Modifica.jpg

TAN_4868.jpg

TAN_4881.jpg

TAN_4922.jpg

TAN_4978.jpg

TAN_5015.jpg

TAN_5062.jpg

TAN_5036.jpg

TAN_5041.jpg

TAN_5183.jpg

TAN_5269.jpg

TAN_5320.jpg

TAN_5375.jpg
TAN_5397.jpg

TAN_5383.jpg

TAN_5417.jpg

TAN_5473.jpg

TAN_5500.jpg

TAN_5557.jpg

TAN_5688.jpg

TAN_5716.jpg

TAN_5723.jpg

UNICATT_04.jpg

UNICATT_05.jpg

UNICATT_15.jpg

UNICATT_03.jpg

UNICATT_16.jpg

IMG_2550.jpeg

unicatt_corriere.jpeg

IMG_4189.jpg

unicatt_ig.jpg

IMG_3010.png

IMG_3011.png

IMG_3879.jpeg

IMG_4187.jpeg
